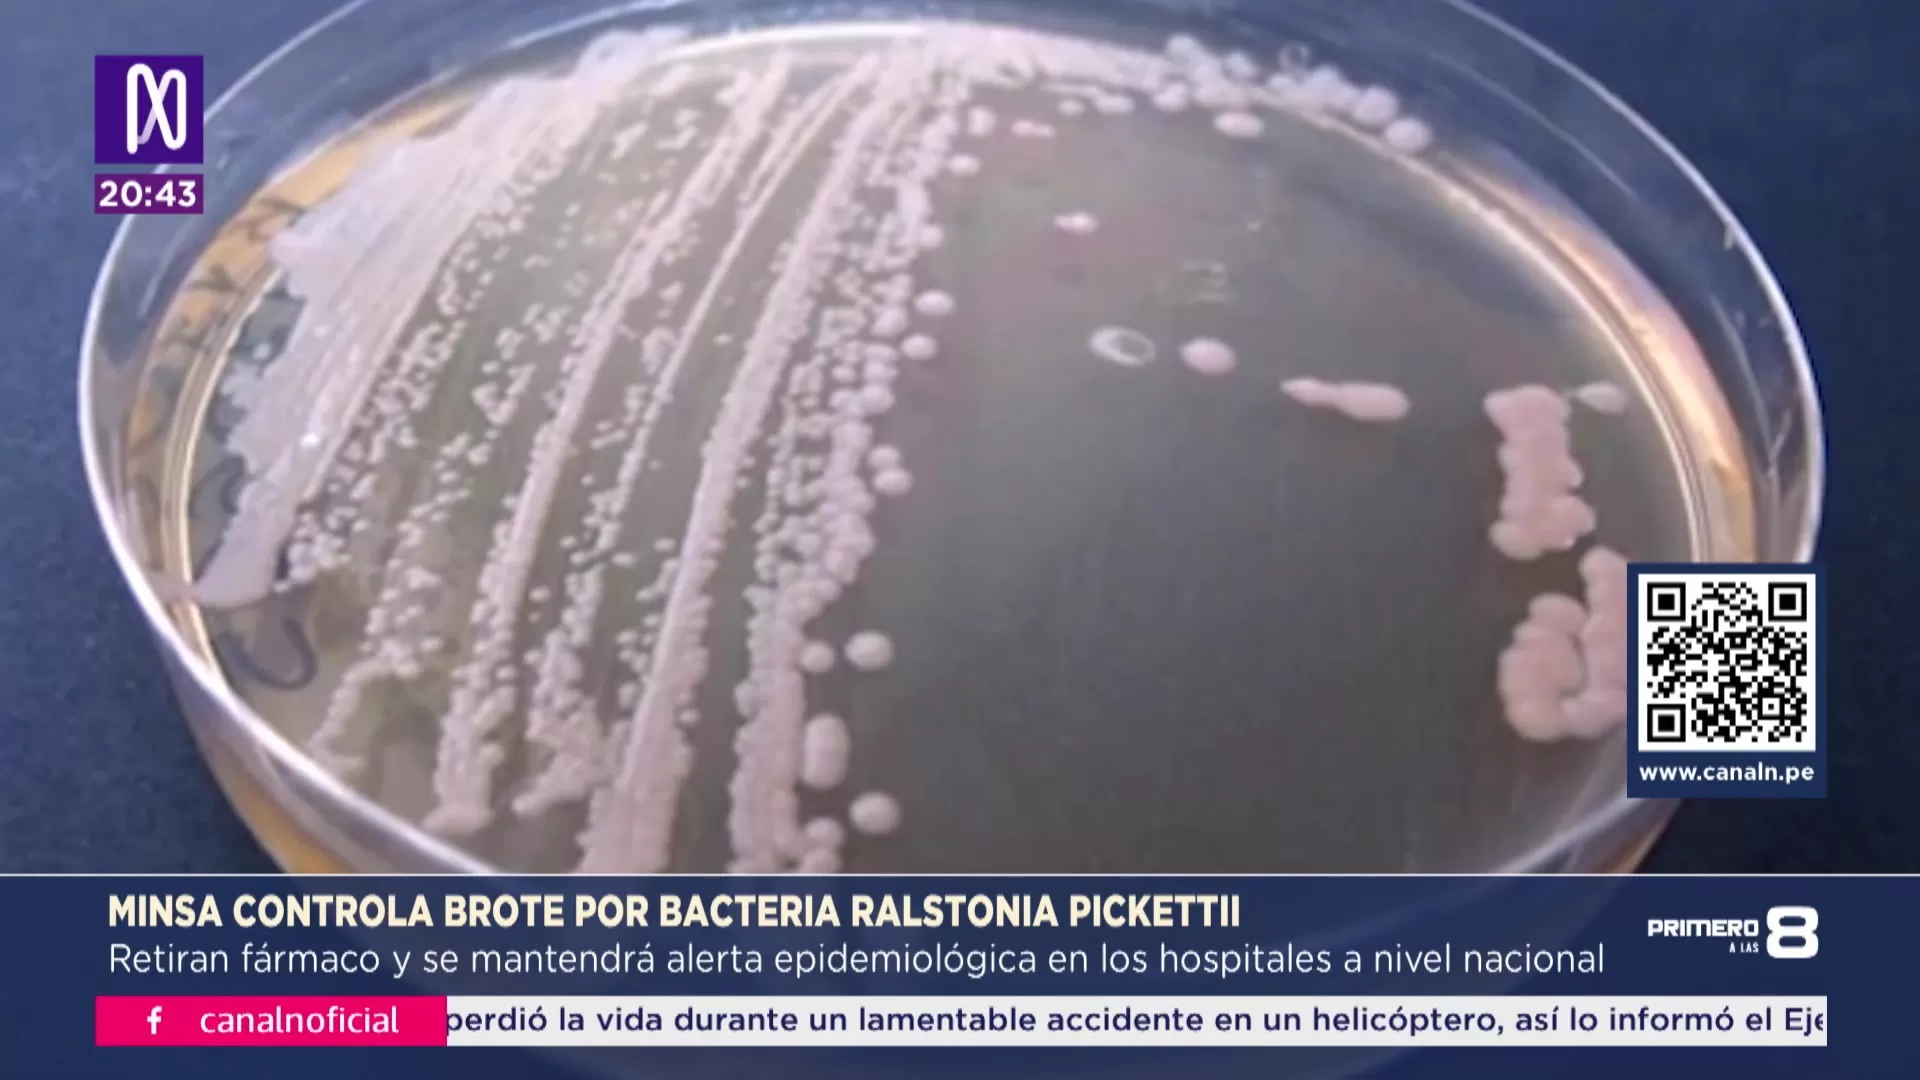

Minsa retiró el 99,8% del medicamento Edetoxin tras contaminación

El Ministerio de Salud informó que el 99,8 % del medicamento Edetoxin fue retirado tras detectar un brote bacteriano. Se suspendió el registro del producto y hay una alerta activa.
El Ministerio de Salud (Minsa) informó que se ha retirado el 99,8% del medicamento Edetoxin, tras detectarse un brote de infecciones intrahospitalarias asociado a la bacteria Ralstonia pickettii. El lote afectado fue inmovilizado completamente, según confirmó el viceministro de Salud Pública, Ricardo Peña.
El medicamento, usado exclusivamente en ambientes hospitalarios para sedación de pacientes críticos, no es prescrito de manera ambulatoria. Las autoridades aseguran que la situación está bajo control.

Lote contaminado fue identificado y retirado
El producto comprometido corresponde al lote ABO25001 del Edetoxin 200 mcg/2 mL, fabricado en India e importado por Nordic Pharmaceutical Company S.A.C.. La alerta se emitió luego de que se detectaran 28 pacientes infectados en distintos centros hospitalarios entre agosto y septiembre.
El primer caso se registró el 22 de octubre en el Instituto Nacional de Salud del Niño San Borja, donde se identificaron 13 infecciones. Otros casos se reportaron en tres hospitales adicionales, una clínica privada y un centro de diálisis.
Brote vinculado a bacterias en unidades UCI
La bacteria Ralstonia pickettii es un microorganismo ambiental de baja virulencia. Sin embargo, su presencia en el medicamento Edetoxin generó una alerta epidemiológica por su uso en pacientes hospitalizados con condiciones críticas. La Alerta Sanitaria N.º116-2025 fue emitida para inmovilizar de inmediato el lote afectado.
Durante los análisis de calidad, se detectó el crecimiento bacteriano en ensayos de esterilidad realizados sobre el lote contaminado.

Acciones inmediatas del Ministerio de Salud
El Minsa ordenó la inmovilización del 100% del lote contaminado. De las 24.000 ampollas distribuidas, más del 84% fue recuperado en las primeras 40 horas, según cifras oficiales. Posteriormente, se alcanzó el retiro del 99,8%, como confirmó el viceministro Peña.
También se dispuso el cierre temporal del laboratorio importador por fallas en los procedimientos de manufactura y trazabilidad. Además, se suspendió el registro sanitario del producto y se evalúan 64 registros adicionales vinculados al mismo laboratorio.

Sin nexo causal con fallecimientos registrados
El Minsa informó que tres pacientes fallecieron en paralelo al brote, pero aclaró que las muertes se deben a causas subyacentes de sus enfermedades. No se ha establecido un vínculo directo con el medicamento Edetoxin.
Ricardo Peña afirmó que la situación "está controlada" y que no existe un nexo causal confirmado entre el fármaco y los decesos. Quince de los pacientes afectados ya fueron dados de alta.

Acciones legales y procedimientos de inspección
La Procuraduría del Minsa fue notificada para iniciar las acciones legales correspondientes contra los responsables. Asimismo, más de 20 inspectores han sido desplegados a nivel nacional para verificar la recuperación total del lote y vigilar la seguridad de otros productos.
El Centro Nacional de Epidemiología mantiene la alerta para reforzar las medidas de prevención y control en todos los establecimientos de salud del país.
Investigación preliminar en Indecopi
De manera paralela, el Indecopi abrió una investigación preliminar contra Nordic Pharmaceutical Company S.A.C. El análisis determinó que el lote ABO25001 no cumplía con los parámetros de esterilidad requeridos.
La institución también activó canales para que los usuarios reporten posibles afectaciones y solicitó información oficial sobre las medidas tomadas por la empresa para mitigar el riesgo.
El Ministerio de Salud del Perú retiró el 99,8% del medicamento Edetoxin tras identificar un brote bacteriano causado por la bacteria Ralstonia pickettii. El lote involucrado, utilizado en pacientes de UCI, fue importado por Nordic Pharmaceutical Company desde India. Se confirmaron 28 casos de infección, aunque no se atribuyen fallecimientos directamente al fármaco. El Minsa ordenó el cierre temporal del laboratorio importador y suspendió el registro sanitario del producto. La alerta epidemiológica sigue vigente. Indecopi abrió una investigación preliminar para determinar responsabilidades y verificar las medidas correctivas adoptadas.





